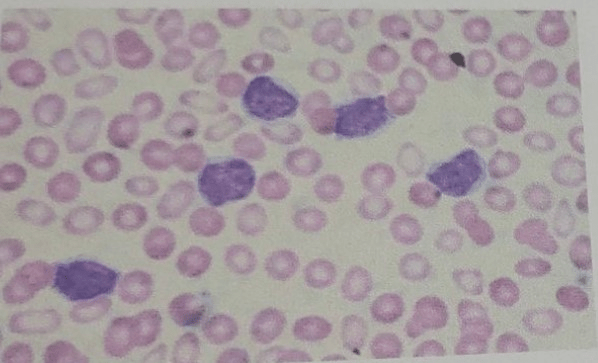
alt

SMP Biologi: Pertanyaan, Jawaban, Latihan Soal & Pembahasan
Urutkan
Saska A
01 November 2022 13:27
1
Irema O
01 November 2022 04:28
5
Falco P
01 November 2022 04:28
13
Episcia R
01 November 2022 04:27

2
Irema O
01 November 2022 04:27
1
Episcia R
01 November 2022 04:27
1
Gmelina A
01 November 2022 04:09
1
Bagian dari ginjal yang berfungsi penting dalam penyaringan darah adalah....
Pembahasan:
1
4.0
Perhatikan gambar sistem reproduksi wanita berikut!

Tuliskan nama bagian-bagian yang ditunjuk!
Pembahasan:
2
5.0
Masuknya atau dimasukkannya makhluk hidup, zat atau energi ke dalam lingkungan oleh kegiatan manusia atau oleh proses alam sehingga kualitas lingkungan turun sampai tingkatan tertentu yang menyebabkan lingkungan menjadi kurang atau tidak dapat berfungsi lagi sesuai dengan peruntukannya dinamakan....
Pembahasan:
2
3.7
Getah empedu berfungsi untuk ...
Pembahasan:
1
4.7
Jelaskan dan berikan contoh komponen ekosistem berdasarkan fungsinya!
Pembahasan:
1
3.0
Perbedaan warna kulit antara seseorang dengan orang yang lainnya disebabkan karena adanya perbedaan pigmen melanin yang ada di lapisan ....
Pembahasan:
1
5.0
Bagian pada ginjal yang berfungsi menampung urine sesungguhnya adalah ....
Pembahasan:
1
3.6
Penyakit ginjal yang ditandai adanya albumin dan protein dalam urine adalah...
Pembahasan:
1
4.0
Jelaskan dampak rusaknya vegetasi tumbuhan di suatu ekosistem dari sisi ekonomi dan kesejahteraan masyarakat !
Pembahasan:
1
4.6
Apa manfaat air di muka bumi setelah kamu mengetahui potensinya di muka bumi?
Pembahasan:
11
4.6
RUANGGURU HQ
Jl. Dr. Saharjo No.161, Manggarai Selatan, Tebet, Kota Jakarta Selatan, Daerah Khusus Ibukota Jakarta 12860
Produk Ruangguru
Bantuan & Panduan
Hubungi Kami
©2026 Ruangguru. All Rights Reserved PT. Ruang Raya Indonesia










